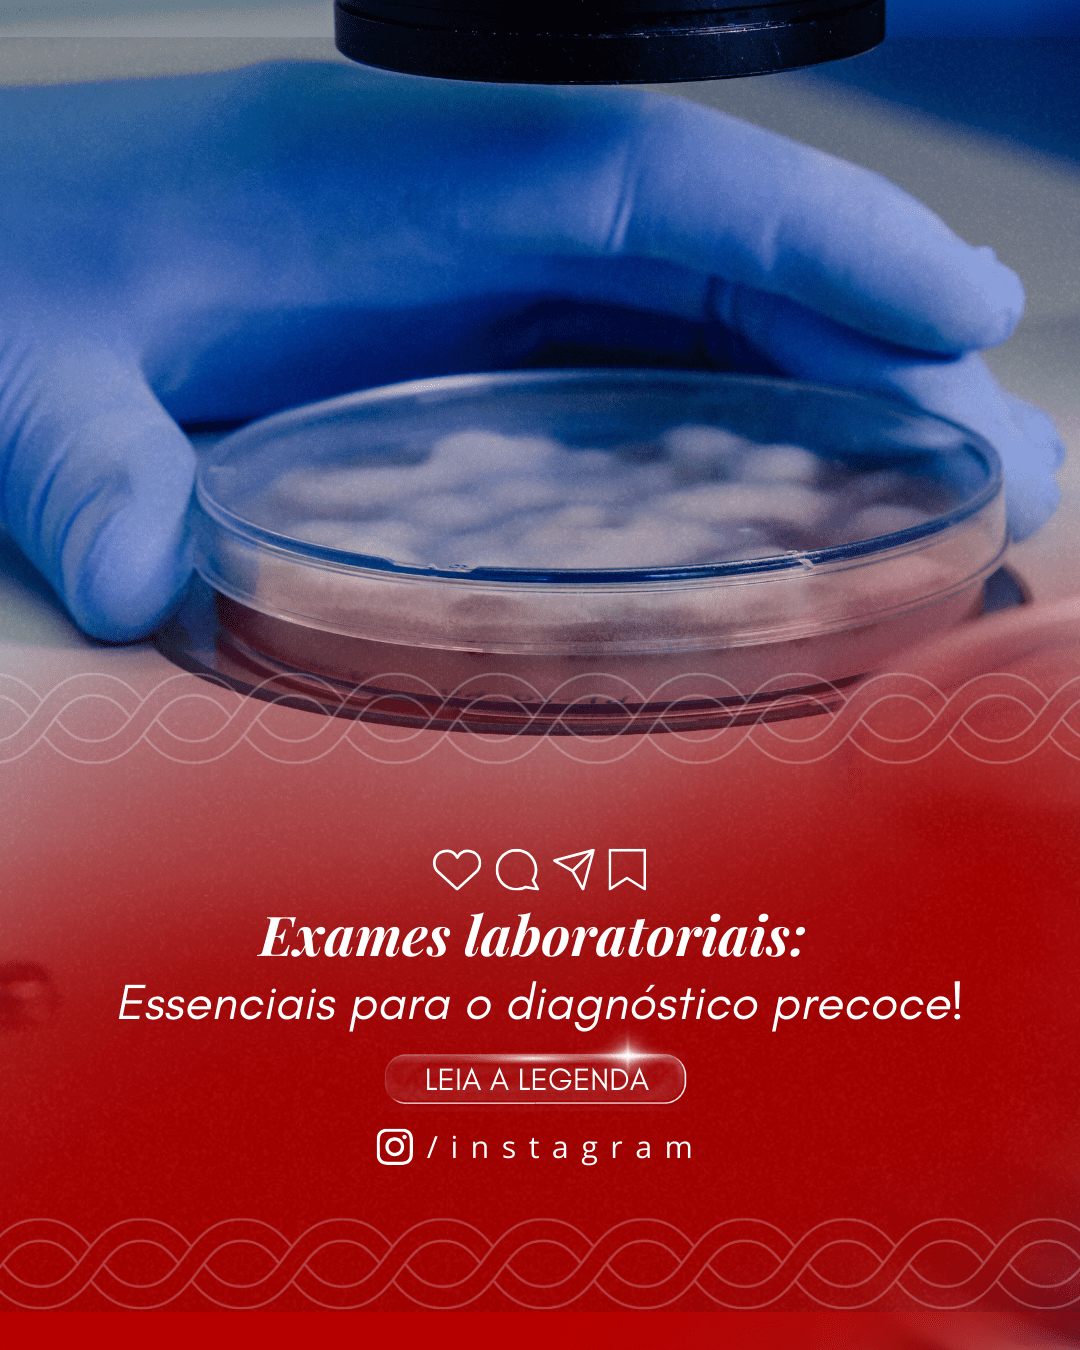

Agilidade
Posts prontos e 100% editáveis no Canva para personalizar em minutos.
Turbine sua presença digital com posts estratégicos 100% editáveis | Legendas prontas, visual impactante e conteúdo especializado para atrair mais clientes. Ter um Perfil Profissional não precisa ser difícil!

Tudo pensado para facilitar sua rotina e aumentar seus resultados no Instagram.
Posts prontos e 100% editáveis no Canva para personalizar em minutos.
Layouts pensados para engajar e transformar seguidores em clientes.
Conjunto de artes + complementos para um feed coerente e profissional.
Você terá acesso por tempo indeterminado ao material.
Material totalmente editável no Canva gratuito — conteúdo criado para o seu nicho, com legendas prontas e já atualizado para o novo formato retrato do feed.

As artes apresentadas neste site correspondem exatamente aos modelos que serão enviados após a compra. Conclua o pedido apenas se tiver certeza de que os designs atendem às suas expectativas.
Tudo que precisa para publicar com qualidade e agilidade — já prontinho para editar no Canva.
Conheça as artes – 50 artes incríveis disponíveis! ✨
Assista ao vídeo para conhecer as postagens incríveis que transformam seu Instagram!
Passo a passo simples para você acessar seus packs imediatamente.
Após o pagamento, você recebe um e-mail automático com o link de acesso.
Crie sua senha e entre na área de membros para visualizar e baixar os conteúdos.
Abra no Canva gratuito, edite cores, textos e imagens em poucos cliques.
Baixe e publique com qualidade profissional no Instagram.
Tire suas dúvidas antes de adquirir. Se faltar algo, chama a gente! 💛
Não. Todos os materiais foram pensados para a versão gratuita do Canva. É só abrir, editar e baixar e postar.
Assim que o pagamento é aprovado, você recebe imediatamente o link por e-mail para acessar e baixar tudo.
Com certeza! Os packs são 100% editáveis. Você troca textos, cores, fotos e logotipo em poucos cliques.
Pode usar para posts próprios e de clientes. Apenas não revenda os arquivos como se fossem packs originais.
Por menos de R$ 1,00 por post, transforme seu perfil e publique com consistência e qualidade.
Por apenas R$ 47,90